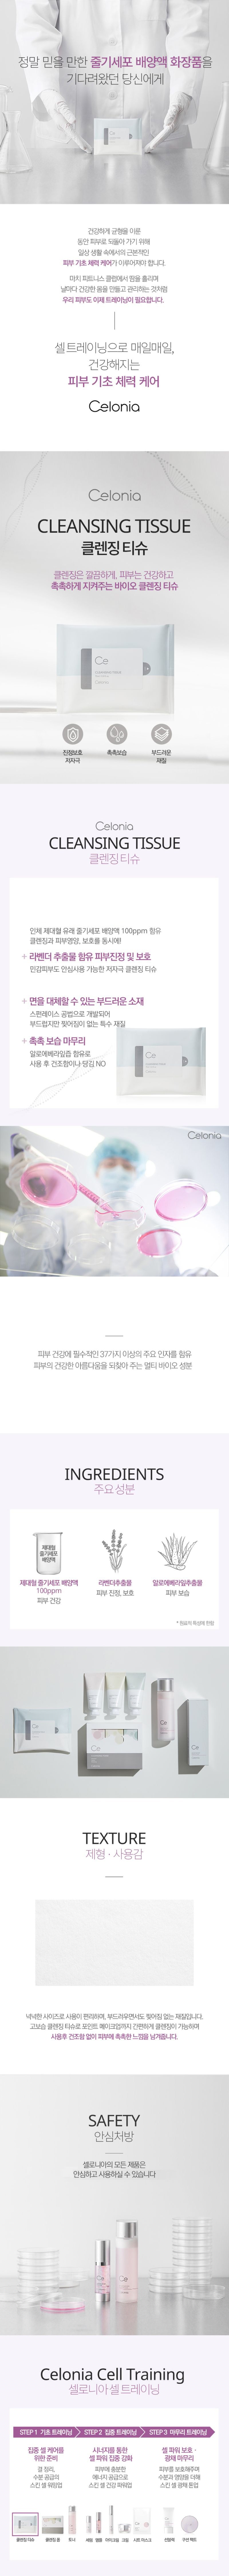

Introducing the Cellonia Cleansing Tissue 72 ml, your ultimate companion for effortless skincare on the go. Designed to deliver a thorough cleanse, these luxurious tissues are perfect for removing makeup, dirt, and impurities, leaving your skin feeling refreshed and rejuvenated.
- Convenient 72 ml pack, ideal for travel or daily use
- Infused with nourishing ingredients to hydrate and soothe the skin
- Soft and gentle texture suitable for all skin types
- Alcohol-free formulation to prevent skin drying
- Resealable packaging to maintain freshness
Experience the benefits of a deep cleanse without the hassle. Cellonia Cleansing Tissues are perfect for quick touch-ups or a full cleanse at the end of your day. Their gentle formula ensures your skin remains soft, smooth, and irritation-free, making them ideal for sensitive skin.
Crafted from high-quality fabrics, these tissues are both durable and effective. For best results, use daily, and remember to reseal the pack to keep tissues moist. Elevate your skincare routine with Cellonia, where convenience meets quality.









Reviews
There are no reviews yet.